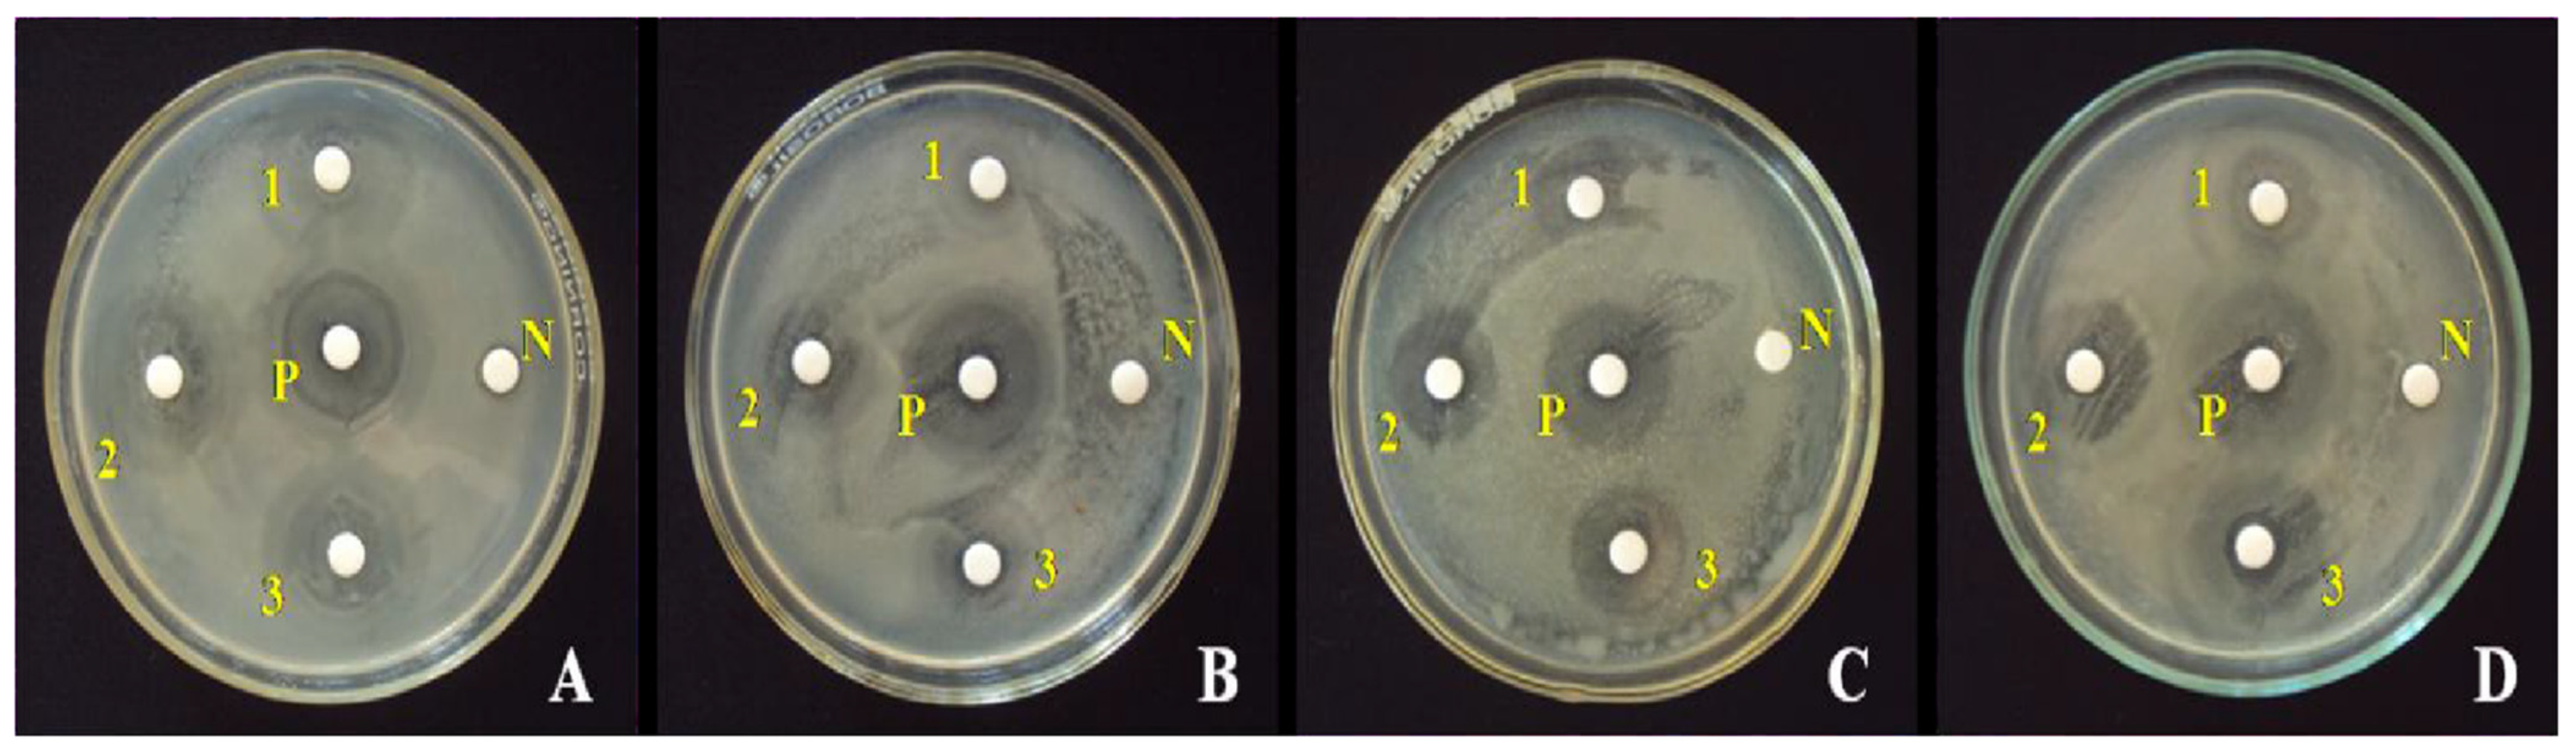
Nanomaterials 15 00609 g012

Hydrothermal ZnO Nanomaterials: Tailored Properties and Infinite Possibilities
Abstract
1. Introduction
2. Features and Advantages of Hydrothermal Synthesis
3. Advanced Hydrothermal Synthesis of ZnO-Based Nanomaterials
3.1. Morphology and Size Control
3.2. Doping Effects on ZnO NPs: Metal and Non-Metal Modifications
3.3. ZnO-Based Nanocomposites
3.4. ZnO-Based Core-Shell NPs
4. Applications of ZnO-Based Nanomaterials
4.1. Sensing
4.2. Photocatalysis
4.2.1. Dye Degradation
4.2.2. Water Splitting
4.2.3. Pesticide Removal
4.3. Optical and Electromagnetic Property-Based Applications
4.4. Microorganism Control
4.5. Solar Cells
4.6. Nanofluids for Heat Transfer
4.7. Other Applications
4.7.1. ZnO/Polymer Nanocomposites
4.7.2. ZnO/Activated Carbon Composites for Supercapacitors
4.7.3. ZnO-Based Hybrid Supercapacitor Electrodes
5. Summary and Conclusions
6. Future Directions in the Hydrothermal Synthesis of ZnO Nanomaterials
Author Contributions
Funding
Conflicts of Interest
References
- Singh, P.; Kumar, R.; Singh, R.K. Progress on Transition Metal-Doped ZnO Nanoparticles and Its Application. Ind. Eng. Chem. Res. 2019, 58, 17130–17163. [Google Scholar] [CrossRef]
- Zhao, S.; Shen, Y.; Yan, X.; Zhou, P.; Yin, Y.; Lu, R.; Han, C.; Cui, B.; Wei, D. Complex-Surfactant-Assisted Hydrothermal Synthesis of One-Dimensional ZnO Nanorods for High-Performance Ethanol Gas Sensor. Sens. Actuators B Chem. 2019, 286, 501–511. [Google Scholar] [CrossRef]
- Qin, C.; Wang, Y.; Gong, Y.; Zhang, Z.; Cao, J. CuO-ZnO Hetero-Junctions Decorated Graphitic Carbon Nitride Hybrid Nanocomposite: Hydrothermal Synthesis and Ethanol Gas Sensing Application. J. Alloys Compd. 2019, 770, 972–980. [Google Scholar] [CrossRef]
- Majumder, S.; Basnet, P.; Mukherjee, J.; Chatterjee, S. Effect of Zinc Precursor on Morphology of ZnO Nanoparticles. AIP Conf. Proc. 2020, 2273, 040006. [Google Scholar] [CrossRef]
- Ghifari, N.; Cinquin, B.; Chahboun, A.; El Abed, A.I. Rhodamine b Doped Zno Monodisperse Microcapsules: Droplet-Based Synthesis, Dynamics and Self-Organization of Zno Nanoparticles and Dye Molecules. Nanomaterials 2020, 10, 2351. [Google Scholar] [CrossRef]
- Hao, D.; Liu, Y.; Gao, S.; Arandiyan, H.; Bai, X.; Kong, Q.; Wei, W.; Shen, P.K.; Ni, B.J. Emerging Artificial Nitrogen Cycle Processes through Novel Electrochemical and Photochemical Synthesis. Mater. Today 2021, 46, 212–233. [Google Scholar] [CrossRef]
- Zhu, L.; Li, Y.; Zeng, W. Hydrothermal Synthesis of Hierarchical Flower-like ZnO Nanostructure and Its Enhanced Ethanol Gas-Sensing Properties. Appl. Surf. Sci. 2018, 427, 281–287. [Google Scholar] [CrossRef]
- Pan, Y.; Zuo, J.; Hou, Z.; Huang, Y.; Huang, C. Preparation of Electrochemical Sensor Based on Zinc Oxide Nanoparticles for Simultaneous Determination of AA, DA, and UA. Front. Chem. 2020, 8, 592538. [Google Scholar] [CrossRef]
- Otis, G.; Ejgenberg, M.; Mastai, Y. Solvent-Free Mechanochemical Synthesis of Zno Nanoparticles by High-Energy Ball Milling of ε-Zn(Oh)2 Crystals. Nanomaterials 2021, 11, 238. [Google Scholar] [CrossRef]
- Petrović, Ž.; Ristić, M.; Musić, S.; Sepiol, B.; Peterlik, H. The Formation of ZnO Nanoparticles from Zinc Gluconate. Ceram. Int. 2015, 41, 4975–4981. [Google Scholar] [CrossRef]
- Rahman, F.; Majed Patwary, M.A.; Bakar Siddique, M.A.; Bashar, M.S.; Haque, M.A.; Akter, B.; Rashid, R.; Haque, M.A.; Royhan Uddin, A.K.M. Green Synthesis of Zinc Oxide Nanoparticles Using Cocos Nucifera Leaf Extract: Characterization, Antimicrobial, Antioxidant and Photocatalytic Activity. R. Soc. Open Sci. 2022, 9, 220858. [Google Scholar] [CrossRef] [PubMed]
- Yang, S.; Li, G.; Qu, C.; Wang, G.; Wang, D. Simple Synthesis of ZnO Nanoparticles on N-Doped Reduced Graphene Oxide for the Electrocatalytic Sensing of l-Cysteine. RSC Adv. 2017, 7, 35004–35011. [Google Scholar] [CrossRef]
- San, X.; Li, M.; Liu, D.; Wang, G.; Shen, Y.; Meng, D.; Meng, F. A Facile One-Step Hydrothermal Synthesis of NiO/ZnO Heterojunction Microflowers for the Enhanced Formaldehyde Sensing Properties. J. Alloys Compd. 2018, 739, 260–269. [Google Scholar] [CrossRef]
- Bhardwaj, R.; Bharti, A.; Singh, J.P.; Chae, K.H.; Goyal, N.; Gautam, S. Structural and Electronic Investigation of ZnO Nanostructures Synthesized under Different Environments. Heliyon 2018, 4, e00594. [Google Scholar] [CrossRef]
- Benhammada, A.; Trache, D.; Kesraoui, M.; Chelouche, S. Hydrothermal Synthesis of Hematite Nanoparticles Decorated on Carbon Mesospheres and Their Synergetic Action on the Thermal Decomposition of Nitrocellulose. Nanomaterials 2020, 10, 968. [Google Scholar] [CrossRef]
- Yoo, R.; Cho, S.; Song, M.J.; Lee, W. Highly Sensitive Gas Sensor Based on Al-Doped ZnO Nanoparticles for Detection of Dimethyl Methylphosphonate as a Chemical Warfare Agent Simulant. Sens. Actuators B Chem. 2015, 221, 217–223. [Google Scholar] [CrossRef]
- Ding, J.; Zhu, S.; Zhu, T.; Sun, W.; Li, Q.; Wei, G.; Su, Z. Hydrothermal Synthesis of Zinc Oxide-Reduced Graphene Oxide Nanocomposites for an Electrochemical Hydrazine Sensor. RSC Adv. 2015, 5, 22935–22942. [Google Scholar] [CrossRef]
- Yan, H.; Song, P.; Zhang, S.; Yang, Z.; Wang, Q. Facile Synthesis, Characterization and Gas Sensing Performance of ZnO Nanoparticles-Coated MoS2 Nanosheets. J. Alloys Compd. 2016, 662, 118–125. [Google Scholar] [CrossRef]
- Agrawal, N.; Munjal, S.; Ansari, M.Z.; Khare, N. Superhydrophobic Palmitic Acid Modified ZnO Nanoparticles. Ceram. Int. 2017, 43, 14271–14276. [Google Scholar] [CrossRef]
- Khayatian, A.; Asgari, V.; Ramazani, A.; Akhtarianfar, S.F.; Kashi, M.A.; Safa, S. Diameter-Controlled Synthesis of ZnO Nanorods on Fe-Doped ZnO Seed Layer and Enhanced Photodetection Performance. Mater. Res. Bull. 2017, 94, 77–84. [Google Scholar] [CrossRef]
- Kamaruzaman, A.; Lah, N.A.C. Formation of ZnO Nanoparticles in the Presence of Tannic Acid. Mater. Today Proc. 2020, 41, 61–64. [Google Scholar] [CrossRef]
- Fujiwara, H.; Suzuki, T.; Pin, C.; Sasaki, K. Localized ZnO Growth on a Gold Nanoantenna by Plasmon-Assisted Hydrothermal Synthesis. Nano Lett. 2020, 20, 389–394. [Google Scholar] [CrossRef] [PubMed]
- Gharagozlou, M.; Naghibi, S. Synthesis of ZnO Nanoparticles Based on Zn Complex Achieved from L-Leucine. J. Chin. Chem. Soc. 2016, 63, 290–297. [Google Scholar] [CrossRef]
- Jiang, J.; Pi, J.; Cai, J. The Advancing of Zinc Oxide Nanoparticles for Biomedical Applications. Bioinorg. Chem. Appl. 2018, 2018, 1062562. [Google Scholar] [CrossRef] [PubMed]
- Sirelkhatim, A.; Mahmud, S.; Seeni, A. Review on Zinc Oxide Nanoparticles: Antibacterial Activity and Toxicity Mechanism. Nano-Micro Lett. 2015, 7, 219–242. [Google Scholar] [CrossRef]
- Ong, C.B.; Ng, L.Y.; Mohammad, A.W. A Review of ZnO Nanoparticles as Solar Photocatalysts: Synthesis, Mechanisms and Applications. Renew. Sustain. Energy Rev. 2018, 81, 536–551. [Google Scholar] [CrossRef]
- Kolodziejczak-Radzimska, A.; Jesionowski, T. Zinc Oxide-from Synthesis to Application: A Review. Materials 2014, 7, 2833–2881. [Google Scholar] [CrossRef]
- Borysiewicz, M.A. ZnO as a Functional Material, a Review. Crystals 2019, 9, 505. [Google Scholar] [CrossRef]
- Beitollahi, H.; Tajik, S.; Nejad, F.G.; Safaei, M. Recent advances in ZnO nanostructure-based electrochemical sensors and biosensors. J. Mater. Chem. B 2020, 8, 5826–5844. [Google Scholar] [CrossRef]
- Rai, P.; Yu, Y. Sensors and Actuators B: Chemical Citrate-Assisted Hydrothermal Synthesis of Single Crystalline ZnO Nanoparticles for Gas Sensor Application. Sens. Actuators B Chem. 2012, 173, 58–65. [Google Scholar] [CrossRef]
- Rai, P.; Song, H.; Kim, Y.; Song, M.; Oh, P.; Yoon, J.; Yu, Y. Microwave Assisted Hydrothermal Synthesis of Single Crystalline ZnO Nanorods for Gas Sensor Application. Mater. Lett. 2012, 68, 90–93. [Google Scholar] [CrossRef]
- Cicero, G. Comparison between ZnO Nanowires Grown by Chemical Vapor Deposition and Hydrothermal Synthesis. Appl. Phys. 2013, 113, 623–632. [Google Scholar] [CrossRef]
- Balachandran, S.; Selvam, K.; Babu, B.; Swaminathan, M. The simple hydrothermal synthesis of Ag–ZnO–SnO2 nanochain and its multiple applications. Dalton Trans. 2013, 42, 16365–16374. [Google Scholar] [CrossRef] [PubMed]
- Kumar, R.; Umar, A.; Kumar, G.; Nalwa, H.S. Antimicrobial properties of ZnO nanomaterials: A review. Ceram. Int. 2017, 43, 3940–3961. [Google Scholar] [CrossRef]
- Kang, Y.; Yu, F.; Zhang, L.; Wang, W.; Chen, L.; Li, Y. Review of ZnO-Based Nanomaterials in Gas Sensors. Solid State Ion. 2021, 360, 115544. [Google Scholar] [CrossRef]
- Pant, B.; Munkhtur, E.; Prasad Ojha, G.; Acharya, J.; Hong, S.-T.; Park, M. Hydrothermally Synthesized ZnO/WS2 Composite with Impressive Photocatalytic, Antibacterial, and Electrochemical Performances. Inorg. Chem. Commun. 2024, 166, 112630. [Google Scholar] [CrossRef]
- Rajakumari, S.; Mohandoss, S.; Sureshkumar, S. Hydrothermal Synthesis of Pd Doped rGO/ZnO Nanocomposite for Effective CBR Dye Degradation and Antibacterial Activities. Chem. Eng. Commun. 2024, 211, 1694–1712. [Google Scholar] [CrossRef]
- Gao, Y.; Zhang, K.; Chen, M.; Zhu, J.; Chen, R.; Wang, H.-L. Unlocking the Potential of Nanostructured ZnO on PPC Membranes: High-Throughput Synthesis, Morphology Tailoring, and Enhanced Antibacterial Activity. ACS Appl. Bio Mater. 2025; ahead of print. [Google Scholar] [CrossRef]
- Abou Zeid, S.; Leprince-Wang, Y. Advancements in ZnO-Based Photocatalysts for Water Treatment: A Comprehensive Review. Crystals 2024, 14, 611. [Google Scholar] [CrossRef]
- Nawaz, A.; Farhan, A.; Maqbool, F.; Ahmad, H.; Qayyum, W.; Ghazy, E.; Rahdar, A.; Díez-Pascual, A.M.; Fathi-karkan, S. Zinc Oxide Nanoparticles: Pathways to Micropollutant Adsorption, Dye Removal, and Antibacterial Actions—A Study of Mechanisms, Challenges, and Future Prospects. J. Mol. Struct. 2024, 1312, 138545. [Google Scholar] [CrossRef]
- Aljeboree, A.M.; Hussein, S.A.; Jawad, M.A.; Alkaim, A.F. Hydrothermal Synthesis of Eco-Friendly ZnO/CNT Nanocomposite and Efficient Removal of Brilliant Green Cationic Dye. Results Chem. 2024, 7, 101364. [Google Scholar] [CrossRef]
- Kang, Z.; Si, H.; Zhang, S.; Wu, J.; Sun, Y.; Liao, Q.; Zhang, Z.; Zhang, Y. Interface Engineering for Modulation of Charge Carrier Behavior in ZnO Photoelectrochemical Water Splitting. Adv. Funct. Mater. 2019, 29, 1808032. [Google Scholar] [CrossRef]
- Huang, J.; Yin, Z.; Zheng, Q. Applications of ZnO in Organic and Hybrid Solar Cells. Energy Environ. Sci. 2011, 4, 3861–3877. [Google Scholar] [CrossRef]
- Yaka, A.P.; Caglar, Y.; Caglar, M. Electrical Performance of Dye-Sensitized Solar Cells Based Nanostructured ZnO Synthesized by Addition CTAB with Hydrothermal Method. Opt. Mater. 2024, 149, 114985. [Google Scholar] [CrossRef]
- Moosavi, M.; Goharshadi, E.K.; Youssefi, A. Fabrication, Characterization, and Measurement of Some Physicochemical Properties of ZnO Nanofluids. Int. J. Heat Fluid Flow 2010, 31, 599–605. [Google Scholar] [CrossRef]
- Dawood, H.K.; Alfellag, M.A.; Abed, W.M.; Hameed, M. Hydrothermal Performance Analysis of Hybrid Nanofluid Flow in Minichannel Heat Sink Equipped with Secondary Inclined Channels and Pins. J. Therm. Anal. Calorim. 2025. [Google Scholar] [CrossRef]
- Huber, F.; Madel, M.; Reiser, A.; Bauer, S.; Thonke, K. New CVD-Based Method for the Growth of High-Quality Crystalline Zinc Oxide Layers. J. Cryst. Growth 2016, 445, 58–62. [Google Scholar] [CrossRef]
- Bai, M.; Chen, M.; Li, X.; Wang, Q. One-Step CVD Growth of ZnO Nanorod/SnO2 Film Heterojunction for NO2 Gas Sensor. Sens. Actuators B Chem. 2022, 373, 132738. [Google Scholar] [CrossRef]
- Jubu, P.R.; Yam, F.K.; Kyesmen, P.I. Structural, Optical and Electrochemical Transient Photoresponse Properties of ZnO/Ga2O3 Nanocomposites Prepared by Two-Step CVD Method. Int. J. Hydrogen Energy 2021, 46, 33087–33097. [Google Scholar] [CrossRef]
- Li, H.; Wang, J.; Liu, H.; Zhang, H.; Li, X. Zinc Oxide Films Prepared by Sol–Gel Method. J. Cryst. Growth 2005, 275, e943–e946. [Google Scholar] [CrossRef]
- Patel, M.; Mishra, S.; Verma, R.; Shikha, D. Synthesis of ZnO and CuO Nanoparticles via Sol Gel Method and Its Characterization by Using Various Technique. Discov. Mater. 2022, 2, 1. [Google Scholar] [CrossRef]
- Ondo-Ndong, R.; Pascal-Delannoy, F.; Boyer, A.; Giani, A.; Foucaran, A. Structural Properties of Zinc Oxide Thin Films Prepared by r.f. Magnetron Sputtering. Mater. Sci. Eng. B 2003, 97, 68–73. [Google Scholar] [CrossRef]
- Wang, G.; Chen, T.; Guo, L.; Wang, H.; Wang, X.; Zeng, H.; Feng, Y.; Zhao, W.; Wang, Y.; Liu, X.; et al. Chemiresistive N-Butanol Gas Sensors Based on Co3O4@ZnO Hollow-Sphere-Array Thin Films Prepared by Template-Assisted Magnetron Sputtering. Sens. Actuators B Chem. 2024, 413, 135862. [Google Scholar] [CrossRef]
- Chubenko, E.B.; Klyshko, A.A.; Bondarenko, V.P.; Balucani, M. Electrochemical Deposition of Zinc Oxide on a Thin Nickel Buffer Layer on Silicon Substrates. Electrochim. Acta 2011, 56, 4031–4036. [Google Scholar] [CrossRef]
- Mehrvarz, A.; Khalil-Allafi, J.; Khosrowshahi, A.K. Biocompatibility and Antibacterial Behavior of Electrochemically Deposited Hydroxyapatite/ZnO Porous Nanocomposite on NiTi Biomedical Alloy. Ceram. Int. 2022, 48, 16326–16336. [Google Scholar] [CrossRef]
- Alver, U.; Kılınç, T.; Bacaksız, E.; Küçükömeroğlu, T.; Nezir, S.; Mutlu, İ.H.; Aslan, F. Synthesis and Characterization of Spray Pyrolysis Zinc Oxide Microrods. Thin Solid Films 2007, 515, 3448–3451. [Google Scholar] [CrossRef]
- Rabeel, M.; Javed, S.; Khan, R.; Akram, M.A.; Rehman, S.; Kim, D.; Khan, M.F. Controlling the Wettability of ZnO Thin Films by Spray Pyrolysis for Photocatalytic Applications. Materials 2022, 15, 3364. [Google Scholar] [CrossRef]
- Alasmari, A.; Awad, A.A.; Aboud, A.A. Investigating the Influence of Yttrium Doping on Physical Properties of ZnO Thin Films Deposited via Spray Pyrolysis. Opt. Mater. 2024, 148, 114899. [Google Scholar] [CrossRef]
- Ou, C.; Sanchez-Jimenez, P.E.; Datta, A.; Boughey, F.L.; Whiter, R.A.; Sahonta, S.-L.; Kar-Narayan, S. Template-Assisted Hydrothermal Growth of Aligned Zinc Oxide Nanowires for Piezoelectric Energy Harvesting Applications. ACS Appl. Mater. Interfaces 2016, 8, 13678–13683. [Google Scholar] [CrossRef]
- Darr, J.A.; Zhang, J.; Makwana, N.M.; Weng, X. Continuous Hydrothermal Synthesis of Inorganic Nanoparticles: Applications and Future Directions. Chem. Rev. 2017, 117, 11125–11238. [Google Scholar] [CrossRef]
- Yang, G.; Park, S.J. Conventional and Microwave Hydrothermal Synthesis and Application of Functional Materials: A Review. Materials 2019, 12, 1177. [Google Scholar] [CrossRef]
- Sonali, S.; Jena, I.; Rout, S.K. A Comparative Study of Synthesis of ZnO Nano Particles: Hydrothermal and Modified Combustion Routes. Mater. Today Proc. 2020, 33, 4966–4970. [Google Scholar] [CrossRef]
- Parihar, V.; Raja, M.; Paulose, R. A Brief Review of Structural, Electrical and Electrochemical Properties of Zinc Oxide Nanoparticles. Rev. Adv. Mater. Sci. 2018, 53, 119–130. [Google Scholar] [CrossRef]
- Kim, E.B.; Ameen, S.; Akhtar, M.S.; Shin, H.S. Iron-Nickel Co-Doped ZnO Nanoparticles as Scaffold for Field Effect Transistor Sensor: Application in Electrochemical Detection of Hexahydropyridine Chemical. Sens. Actuators B Chem. 2018, 275, 422–431. [Google Scholar] [CrossRef]
- Young, S.J.; Chu, Y.L. Hydrothermal Synthesis and Improved CHOH-Sensing Performance of ZnO Nanorods with Adsorbed Au NPs. IEEE Trans. Electron Devices 2021, 68, 1886–1891. [Google Scholar] [CrossRef]
- Romeiro, F.C.; Rodrigues, M.A.; Silva, L.A.J.; Catto, A.C.; da Silva, L.F.; Longo, E.; Nossol, E.; Lima, R.C. rGO-ZnO Nanocomposites for High Electrocatalytic Effect on Water Oxidation Obtained by Microwave-Hydrothermal Method. Appl. Surf. Sci. 2017, 423, 743–751. [Google Scholar] [CrossRef]
- Tan, H.J.; Zainal, Z.; Talib, Z.A.; Lim, H.N.; Shafie, S.; Tan, S.T.; Tan, K.B.; Bahrudin, N.N. Synthesis of High Quality Hydrothermally Grown ZnO Nanorods for Photoelectrochemical Cell Electrode. Ceram. Int. 2021, 47, 14194–14207. [Google Scholar] [CrossRef]
- Ocakoglu, K.; Mansour, S.A.; Yildirimcan, S.; Al-Ghamdi, A.A.; El-Tantawy, F.; Yakuphanoglu, F. Microwave-Assisted Hydrothermal Synthesis and Characterization of ZnO Nanorods. Spectrochim. Acta Part Mol. Biomol. Spectrosc. 2015, 148, 362–368. [Google Scholar] [CrossRef]
- Debnath, T.; Saha, P.; Patra, N.; Das, S.; Sutradhar, S. Hydrothermal Process Assists Undoped and Cr-Doped Semiconducting ZnO Nanorods: Frontier of Dielectric Property. J. Appl. Phys. 2018, 123, 194101. [Google Scholar] [CrossRef]
- Tomai, T.; Tang, L.; Yoko, A.; Omura, Y.; Seong, G.; Adschiri, T. Facile Regeneration Strategy for Facet-Controlled Nanocatalysts via the Dissolution-Reprecipitation Process Promoted by an Organic Modifier. Chem. Mater. 2021, 33, 7780–7784. [Google Scholar] [CrossRef]
- Edalati, K.; Shakiba, A.; Vahdati-Khaki, J.; Zebarjad, S.M. Low-Temperature Hydrothermal Synthesis of ZnO Nanorods: Effects of Zinc Salt Concentration, Various Solvents and Alkaline Mineralizers. Mater. Res. Bull. 2016, 74, 374–379. [Google Scholar] [CrossRef]
- Bharti, D.B.; Bharati, A.V. Synthesis of ZnO Nanoparticles Using a Hydrothermal Method and a Study Its Optical Activity. Luminescence 2017, 32, 317–320. [Google Scholar] [CrossRef]
- Fang, M.; Tang, C.M.; Liu, Z.W. Microwave-Assisted Hydrothermal Synthesis of Cu-Doped ZnO Single Crystal Nanoparticles with Modified Photoluminescence and Confirmed Ferromagnetism. J. Electron. Mater. 2018, 47, 1390–1396. [Google Scholar] [CrossRef]
- Vlazan, P.; Ursu, D.H.; Irina-Moisescu, C.; Miron, I.; Sfirloaga, P.; Rusu, E. Structural and Electrical Properties of TiO2/ZnO Core-Shell Nanoparticles Synthesized by Hydrothermal Method. Mater. Charact. 2015, 101, 153–158. [Google Scholar] [CrossRef]
- Jamshidi, M.; Ghaedi, M.; Dashtian, K.; Hajati, S.; Bazrafshan, A.A. Sonochemical Assisted Hydrothermal Synthesis of ZnO: Cr Nanoparticles Loaded Activated Carbon for Simultaneous Ultrasound-Assisted Adsorption of Ternary Toxic Organic Dye: Derivative Spectrophotometric, Optimization, Kinetic and Isotherm Study. Ultrason. Sonochem. 2016, 32, 119–131. [Google Scholar] [CrossRef]
- Hu, J.; Zhou, Y.; Sheng, X. Hydrothermal Synthesis of ZnO@polysiloxane Microspheres and Their Application in Preparing Optical Diffusers. RSC Adv. 2015, 5, 17064–17069. [Google Scholar] [CrossRef]
- Chen, C.; Bi, W.; Xia, Z.; Yuan, W.; Li, L. Hydrothermal Synthesis of the CuWO4/ZnO Composites with Enhanced Photocatalytic Performance. ACS Omega 2020, 5, 13185–13195. [Google Scholar] [CrossRef]
- Chang, T.H.; Lu, Y.C.; Yang, M.J.; Huang, J.W.; Linda Chang, P.F.; Hsueh, H.Y. Multibranched Flower-like ZnO Particles from Eco-Friendly Hydrothermal Synthesis as Green Antimicrobials in Agriculture. J. Clean. Prod. 2020, 262, 121342. [Google Scholar] [CrossRef]
- Ramesh, A.M.; Shivanna, S. Hydrothermal Synthesis of MoO3/ZnO Heterostructure with Highly Enhanced Photocatalysis and Their Environmental Interest. J. Environ. Chem. Eng. 2021, 9, 105040. [Google Scholar] [CrossRef]
- Hosseinian, A.; Sheybanifard, Z.; Mahjoubb, A.R. Investigation of Ph Effect on the Hydrothermal Synthesis of Highly Efficient ZnO Nanostructures as Photocatalyst. Inorg. Nano-Met. Chem. 2017, 47, 302–307. [Google Scholar] [CrossRef]
- Zhang, J.; Liu, T.; Zhang, Y.; Zeng, W.; Pan, F.; Peng, X. Hydrothermal Synthesis and Growth Mechanisms of Different ZnO Nanostructures and Their Gas-Sensing Properties. J. Mater. Sci. Mater. Electron. 2015, 26, 1347–1353. [Google Scholar] [CrossRef]
- Saranya, A.; Devasena, T.; Sivaram, H.; Jayavel, R. Materials Science in Semiconductor Processing Role of Hexamine in ZnO Morphologies at Di Ff Erent Growth Temperature with Potential Application in Dye Sensitized Solar Cell. Mater. Sci. Semicond. Process. 2018, 92, 108–115. [Google Scholar] [CrossRef]
- Öztürk, S.; Kılınç, N.; Ziya, Z. Fabrication of ZnO Nanorods for NO2 Sensor Applications: Effect of Dimensions and Electrode Position. J. Alloys Compd. 2013, 581, 196–201. [Google Scholar] [CrossRef]
- Alam, S.; Hossain, M.Z. A Simple Hydrothermal Protocol for the Synthesis of Zinc Oxide Nanorods. Jagannath Univ. J. Sci. 2021, 7, 75–80. [Google Scholar]
- Bulcha, B.; Leta Tesfaye, J.; Anatol, D.; Shanmugam, R.; Dwarampudi, L.P.; Nagaprasad, N.; Bhargavi, V.L.N.; Krishnaraj, R. Synthesis of Zinc Oxide Nanoparticles by Hydrothermal Methods and Spectroscopic Investigation of Ultraviolet Radiation Protective Properties. J. Nanomater. 2021, 2021, 617290. [Google Scholar] [CrossRef]
- Mohan, S.; Vellakkat, M.; Aravind, A.; Reka, U. Hydrothermal Synthesis and Characterization of Zinc Oxide Nanoparticles of Various Shapes under Different Reaction Conditions. Nano Express 2020, 1, 030028. [Google Scholar] [CrossRef]
- Abu Nayem, S.M.; Shah, S.S.; Chaity, S.B.; Biswas, B.K.; Nahar, B.; Aziz, M.A.; Hossain, M.Z. Jute Stick Extract Assisted Hydrothermal Synthesis of Zinc Oxide Nanoflakes and Their Enhanced Photocatalytic and Antibacterial Efficacy. Arab. J. Chem. 2022, 15, 104265. [Google Scholar] [CrossRef]
- Wu, X.; Wei, Z.; Zhang, L.; Zhang, C.; Yang, H.; Jiang, J. Synthesis and Characterization of Fe and Ni Co-Doped ZnO Nanorods Synthesized by a Hydrothermal Method. Ceram. Int. 2014, 40, 14635–14640. [Google Scholar] [CrossRef]
- Nayem, S.M.A.; Hossain, M.Z. Enhanced Photodegradation of Methylene Blue Dye by Ag–ZnO Nanocomposites. J. Bangladesh Chem. Soc. 2021, 33, 53–56. [Google Scholar]
- Senol, S.D.; Ozturk, O.; Terzioğlu, C. Effect of Boron Doping on the Structural, Optical and Electrical Properties of ZnO Nanoparticles Produced by the Hydrothermal Method. Ceram. Int. 2015, 41, 11194–11201. [Google Scholar] [CrossRef]
- Saravanakumar, B.; Mohan, R.; Kim, S.J. Facile Synthesis of Graphene/ZnO Nanocomposites by Low Temperature Hydrothermal Method. Mater. Res. Bull. 2013, 48, 878–883. [Google Scholar] [CrossRef]
- Lu, P.; Zhou, W.; Li, Y.; Wang, J.; Wu, P. Abnormal Room Temperature Ferromagnetism in CuO/ZnO Nanocomposites via Hydrothermal Method. Appl. Surf. Sci. 2017, 399, 396–402. [Google Scholar] [CrossRef]
- Kaneti, Y.V.; Moriceau, J.; Liu, M.; Yuan, Y.; Zakaria, Q.; Jiang, X.; Yu, A. Hydrothermal Synthesis of Ternary α-Fe2O3-ZnO-Au Nanocomposites with High Gas-Sensing Performance. Sens. Actuators B Chem. 2015, 209, 889–897. [Google Scholar] [CrossRef]
- Li, Y.; Jiao, M.; Yang, M. In-Situ Grown Nanostructured ZnO via a Green Approach and Gas Sensing Properties of Polypyrrole/ZnO Nanohybrids. Sens. Actuators B Chem. 2017, 238, 596–604. [Google Scholar] [CrossRef]
- Althubiti, N.A.; Taha, T.A.; Azab, A.A.; Abdelhamid, H.N. ZnO-Based Nanocomposites for Hydrogen Generation via Hydrolysis of Borohydride. J. Sol-Gel Sci. Technol. 2023, 106, 837–846. [Google Scholar] [CrossRef]
- Senthil Kumar, N.; Ganapathy, M.; Sharmila, S.; Shankar, M.; Vimalan, M.; Vetha Potheher, I. ZnO/Ni(OH)2core-Shell Nanoparticles: Synthesis, Optical, Electrical and Photoacoustic Property Analysis; Elsevier B.V.: Amsterdam, The Netherlands, 2017; Volume 703, ISBN 9199429942. [Google Scholar]
- Jain, N.; Kumar, D.; Bhardwaj, K.; Sharma, R.K.; Holovsky, J.; Mishra, M.; Mishra, Y.K.; Sharma, S.K. Heterostructured Core-Shell Metal Oxide-Based Nanobrushes for Ultrafast UV Photodetectors. Mater. Sci. Eng. R Rep. 2024, 160, 100826. [Google Scholar] [CrossRef]
- Nguyen, Q.; Zilli, A.; Celebrano, M.; Baldi, A. Tailoring Core Size, Shell Thickness, and Aluminium Doping of Au@ZnO Core@shell Nanoparticles. J. Mater. Chem. C, 2025; Advance Article. [Google Scholar] [CrossRef]
- Madhubala, V.; Kalaivani, T. Phyto and Hydrothermal Synthesis of Fe3O4@ZnO Core-Shell Nanoparticles Using Azadirachta Indica and Its Cytotoxicity Studies. Appl. Surf. Sci. 2018, 449, 584–590. [Google Scholar] [CrossRef]
- Soltani, S.; Khanian, N.; Rashid, U.; Choong, T.S.Y. Core-Shell ZnO-TiO2 Hollow Spheres Synthesized by in-Situ Hydrothermal Method for Ester Production Application. Renew. Energy 2020, 151, 1076–1081. [Google Scholar] [CrossRef]
- Huynh, H.N.D.; Nguyen, B.G.M.; Dinh, T.M.; Nguyen, N.M.; Tran, C.K.; Nguyen, T.T.; Tran, N.H.T.; La, H.P.P.; Tran, T.T.V.; Duy, L.T.; et al. Enhancing the Performance of ZnO-Based Photodetectors by Forming ZnO/(Cu:ZnO) Core/Shell Nanorods. ACS Appl. Electron. Mater. 2024, 6, 1894–1903. [Google Scholar] [CrossRef]
- Agarwal, S.; Rai, P.; Gatell, E.N.; Llobet, E.; Güell, F.; Kumar, M.; Awasthi, K. Gas Sensing Properties of ZnO Nanostructures (Flowers/Rods)Synthesized by Hydrothermal Method. Sens. Actuators B Chem. 2019, 292, 24–31. [Google Scholar] [CrossRef]
- Zhou, L.; Zeng, W.; Li, Y. A Facile One-Step Hydrothermal Synthesis of a Novel NiO/ZnO Nanorod Composite and Its Enhanced Ethanol Sensing Property. Mater. Lett. 2019, 254, 92–95. [Google Scholar] [CrossRef]
- Zang, W.; Li, P.; Fu, Y.; Xing, L.; Xue, X. Hydrothermal Synthesis of Co-ZnO Nanowire Array and Its Application as Piezo-Driven Self-Powered Humidity Sensor with High Sensitivity and Repeatability. RSC Adv. 2015, 5, 84343–84349. [Google Scholar] [CrossRef]
- Qiao, L.; Jia, X.; Zhang, J.; Yang, J.; Shao, D.; Feng, L.; Song, H. Long-Term, Rapid and Stable Acetone Gas Sensing Performance of Porous rGO/Flower-Shaped ZnO Nanocomposites with a Hydrothermal Synthesis Method. Ceram. Int. 2024, 50, 26879–26887. [Google Scholar] [CrossRef]
- Kim, H.M.; Park, J.H.; Lee, S.K. Fiber Optic Sensor Based on ZnO Nanowires Decorated by Au Nanoparticles for Improved Plasmonic Biosensor. Sci. Rep. 2019, 9, 15605. [Google Scholar] [CrossRef]
- Sinha, M.; Mahapatra, R.; Mondal, B.; Maruyama, T.; Ghosh, R. Ultrafast and Reversible Gas-Sensing Properties of ZnO Nanowire Arrays Grown by Hydrothermal Technique. J. Phys. Chem. C 2016, 120, 3019–3025. [Google Scholar] [CrossRef]
- Wang, L.; Li, Y.; Gao, S.; Yue, W. Unique Hierarchical Sn3O4 Nanoflowers Decorated with ZnO Nanoparticles and Their Formaldehyde Gas Sensing Properties. IOP Conf. Ser. Mater. Sci. Eng. 2020, 729, 012103. [Google Scholar] [CrossRef]
- Yoo, R.; Li, D.; Rim, H.J.; Cho, S.; Lee, H.S.; Lee, W. High Sensitivity in Al-Doped ZnO Nanoparticles for Detection of Acetaldehyde. Sens. Actuators B Chem. 2018, 266, 883–888. [Google Scholar] [CrossRef]
- Li, J.; Liu, H.; Fu, H.; Xu, L.; Jin, H.; Zhang, X.; Wang, L.; Yu, K. Synthesis of 1D α-MoO3/0D ZnO Heterostructure Nanobelts with Enhanced Gas Sensing Properties. J. Alloys Compd. 2019, 788, 248–256. [Google Scholar] [CrossRef]
- Basnet, P.; Chatterjee, S. Structure-Directing Property and Growth Mechanism Induced by Capping Agents in Nanostructured ZnO during Hydrothermal Synthesis—A Systematic Review. Nano-Struct. Nano-Objects 2020, 22, 100426. [Google Scholar] [CrossRef]
- Rangel, R.; Cedeño, V.; Ramos-Corona, A.; Gutiérrez, R.; Alvarado-Gil, J.J.; Ares, O.; Bartolo-Pérez, P.; Quintana, P. Tailoring Surface and Photocatalytic Properties of ZnO and Nitrogen-Doped ZnO Nanostructures Using Microwave-Assisted Facile Hydrothermal Synthesis. Appl. Phys. Mater. Sci. Process. 2017, 123, 552. [Google Scholar] [CrossRef]
- Koutavarapu, R.; Lee, G.; Babu, B.; Yoo, K.; Shim, J. Visible-Light-Driven Photocatalytic Activity of Tiny ZnO Nanosheets Anchored on NaBiS2 Nanoribbons via Hydrothermal Synthesis. J. Mater. Sci. Mater. Electron. 2019, 30, 10900–10911. [Google Scholar] [CrossRef]
- Huang, Q.; Wang, C.; Hao, D.; Wei, W.; Wang, L.; Ni, B.J. Ultralight Biodegradable 3D-g-C3N4 Aerogel for Advanced Oxidation Water Treatment Driven by Oxygen Delivery Channels and Triphase Interfaces. J. Clean. Prod. 2021, 288, 125091. [Google Scholar] [CrossRef]
- Li, X.; Liu, T.; Zhang, Y.; Cai, J.; He, M.; Li, M.; Chen, Z.; Zhang, L. Growth of BiOBr/ZIF-67 Nanocomposites on Carbon Fiber Cloth as Filter-Membrane-Shaped Photocatalyst for Degrading Pollutants in Flowing Wastewater. Adv. Fiber Mater. 2022, 4, 1620–1631. [Google Scholar] [CrossRef]
- Zhai, H.; Liu, Z.; Xu, L.; Liu, T.; Fan, Y.; Jin, L.; Dong, R.; Yi, Y.; Li, Y. Waste Textile Reutilization Via a Scalable Dyeing Technology: A Strategy to Enhance Dyestuffs Degradation Efficiency. Adv. Fiber Mater. 2022, 4, 1595–1608. [Google Scholar] [CrossRef]
- Li, L.; ul Hasan, I.M.; Qiao, J.; He, R.; Peng, L.; Xu, N.; Niazi, N.K.; Zhang, J.-N.; Farwa, F. Copper as a Single Metal Atom Based Photo-, Electro- and Photoelectrochemical Catalyst Decorated on Carbon Nitride Surface for Efficient CO2 Reduction: A Review. Nano Res. Energy 2022, 1, 9120015. [Google Scholar] [CrossRef]
- Kumar, P.; Kundu, V.S.; Kumar, S.; Saharan, B.; Kumar, V.; Chauhan, N. Hydrothermal Synthesis of Cu-ZnO-/TiO2-Based Engineered Nanomaterials for the Efficient Removal of Organic Pollutants and Bacteria from Water. BioNanoScience 2017, 7, 574–582. [Google Scholar] [CrossRef]
- Khalid, A.; Ahmad, P.; Alharthi, A.I.; Muhammad, S.; Khandaker, M.U.; Faruque, M.R.I.; Khan, A.; Din, I.U.; Alotaibi, M.A.; Alzimami, K.; et al. Enhanced Optical and Antibacterial Activity of Hydrothermally Synthesized Cobalt-Doped Zinc Oxide Cylindrical Microcrystals. Materials 2021, 14, 3223. [Google Scholar] [CrossRef]
- Wang, Y.; Ge, S.; Cheng, W.; Hu, Z.; Shao, Q.; Wang, X.; Lin, J.; Dong, M.; Wang, J.; Guo, Z. Microwave Hydrothermally Synthesized Metal-Organic Framework-5 Derived C-Doped ZnO with Enhanced Photocatalytic Degradation of Rhodamine B. Langmuir 2020, 36, 9658–9667. [Google Scholar] [CrossRef]
- Kataria, N.; Garg, V.K. Removal of Congo Red and Brilliant Green Dyes from Aqueous Solution Using Flower Shaped ZnO Nanoparticles; Elsevier B.V.: Amsterdam, The Netherlands, 2017; Volume 5, ISBN 9198120581. [Google Scholar]
- Kumaresan, N.; Ramamurthi, K. Synthesis of ZnO/rGO Nanocomposites by Wet Impregnation Method for Photocatalytic Performance against RhB Dye and 4-Chlorophenol under UV Light Irradiation. J. Mater. Sci. Mater. Electron. 2020, 31, 3361–3374. [Google Scholar] [CrossRef]
- Saikia, L.; Bhuyan, D.; Saikia, M.; Malakar, B.; Dutta, D.K.; Sengupta, P. Photocatalytic Performance of ZnO Nanomaterials for Self Sensitized Degradation of Malachite Green Dye under Solar Light. Appl. Catal. Gen. 2015, 490, 42–49. [Google Scholar] [CrossRef]
- Maleki, A.; Safari, M.; Shahmoradi, B.; Zandsalimi, Y.; Daraei, H.; Gharibi, F. Photocatalytic Degradation of Humic Substances in Aqueous Solution Using Cu-Doped ZnO Nanoparticles under Natural Sunlight Irradiation. Environ. Sci. Pollut. Res. 2015, 22, 16875–16880. [Google Scholar] [CrossRef] [PubMed]
- Worajittiphon, P.; Pingmuang, K.; Inceesungvorn, B.; Wetchakun, N.; Phanichphant, S. Enhancing the Photocatalytic Activity of ZnO Nanoparticles for Efficient Rhodamine B Degradation by Functionalised Graphene Nanoplatelets. Ceram. Int. 2015, 41, 1885–1889. [Google Scholar] [CrossRef]
- Pirsaheb, M.; Shahmoradi, B.; Beikmohammadi, M.; Azizi, E.; Hossini, H.; Md Ashraf, G. Photocatalytic Degradation of Aniline from Aqueous Solutions under Sunlight Illumination Using Immobilized Cr:ZnO Nanoparticles. Sci. Rep. 2017, 7, 1473. [Google Scholar] [CrossRef]
- Zhao, J.; Ge, S.; Pan, D.; Pan, Y.; Murugadoss, V.; Li, R.; Xie, W.; Lu, Y.; Wu, T.; Wujcik, E.K.; et al. Microwave Hydrothermal Synthesis of In2O3-ZnO Nanocomposites and Their Enhanced Photoelectrochemical Properties. J. Electrochem. Soc. 2019, 166, H3074–H3083. [Google Scholar] [CrossRef]
- Ebrahimi, R.; Maleki, A.; Zandsalimi, Y.; Ghanbari, R.; Shahmoradi, B.; Rezaee, R.; Safari, M.; Joo, S.W.; Daraei, H.; Harikaranahalli Puttaiah, S.; et al. Photocatalytic Degradation of Organic Dyes Using WO3 -Doped ZnO Nanoparticles Fixed on a Glass Surface in Aqueous Solution. J. Ind. Eng. Chem. 2019, 73, 297–305. [Google Scholar] [CrossRef]
- Kashinath, L.; Namratha, K.; Byrappa, K. Microwave Assisted Facile Hydrothermal Synthesis and Characterization of Zinc Oxide Flower Grown on Graphene Oxide Sheets for Enhanced Photodegradation of Dyes. Appl. Surf. Sci. 2015, 357, 1849–1856. [Google Scholar] [CrossRef]
- Bazazi, S.; Arsalani, N.; Khataee, A.; Tabrizi, A.G. Comparison of Ball Milling-Hydrothermal and Hydrothermal Methods for Synthesis of ZnO Nanostructures and Evaluation of Their Photocatalytic Performance. J. Ind. Eng. Chem. 2018, 62, 265–272. [Google Scholar] [CrossRef]
- Liu, T.; Li, Y.; Zhang, H.; Wang, M.; Fei, X.; Duo, S.; Chen, Y.; Pan, J.; Wang, W. Tartaric Acid Assisted Hydrothermal Synthesis of Different Flower-like ZnO Hierarchical Architectures with Tunable Optical and Oxygen Vacancy-Induced Photocatalytic Properties. Appl. Surf. Sci. 2015, 357, 516–529. [Google Scholar] [CrossRef]
- Sahoo, G.P.; Samanta, S.; Bhui, D.K.; Pyne, S.; Maity, A.; Misra, A. Hydrothermal Synthesis of Hexagonal ZnO Microstructures in HPMC Polymer Matrix and Their Catalytic Activities. J. Mol. Liq. 2015, 212, 665–670. [Google Scholar] [CrossRef]
- Kumar, S.; Sharma, V.; Bhattacharyya, K.; Krishnan, V. Synergetic Effect of MoS2-RGO Doping to Enhance the Photocatalytic Performance of ZnO Nanoparticles. New J. Chem. 2016, 40, 5185–5197. [Google Scholar] [CrossRef]
- Labhane, P.K.; Patle, L.B.; Sonawane, G.H.; Sonawane, S.H. Fabrication of Ternary Mn Doped ZnO Nanoparticles Grafted on Reduced Graphene Oxide (RGO) Sheet as an Efficient Solar Light Driven Photocatalyst. Chem. Phys. Lett. 2018, 710, 70–77. [Google Scholar] [CrossRef]
- Klubnuan, S.; Suwanboon, S.; Amornpitoksuk, P. Effects of Optical Band Gap Energy, Band Tail Energy and Particle Shape on Photocatalytic Activities of Different ZnO Nanostructures Prepared by a Hydrothermal Method. Opt. Mater. 2016, 53, 134–141. [Google Scholar] [CrossRef]
- Guo, Y.; Lin, S.; Li, X.; Liu, Y. Amino Acids Assisted Hydrothermal Synthesis of Hierarchically Structured ZnO with Enhanced Photocatalytic Activities. Appl. Surf. Sci. 2016, 384, 83–91. [Google Scholar] [CrossRef]
- Wang, Y.; Wang, B.; Xu, Y.; Fang, M.; Wu, Z.; Zhu, W.; Hong, J.; Li, C. Hydrothermal Oxidation Synthesis of Rod-like ZnO and the Influence of Oxygen Vacancy on Photocatalysis. J. Chin. Chem. Soc. 2017, 64, 188–194. [Google Scholar] [CrossRef]
- Louis, J.; Kavitha, M.K.; Anjana, V.; Jayaraj, M.K.; John, H. A Facile Surfactant Assisted Hydrothermal Synthesis of ZnO and Graphene Loaded ZnO for Efficient Photocatalytic Self-Cleaning. Mater. Res. Express 2019, 6, 1250i4. [Google Scholar] [CrossRef]
- Kumaresan, N.; Ramamurthi, K.; Ramesh Babu, R.; Sethuraman, K.; Moorthy Babu, S. Hydrothermally Grown ZnO Nanoparticles for Effective Photocatalytic Activity. Appl. Surf. Sci. 2017, 418, 138–146. [Google Scholar] [CrossRef]
- Nayem, S.M.A.; Islam, S.; Aziz, M.A.; Ahammad, A.J.S. Mechanistic Insight into Hydrothermally Prepared Molybdenum-Based Electrocatalyst for Overall Water Splitting. Electrochimica Acta 2023, 445, 142050. [Google Scholar] [CrossRef]
- Babu, E.S.; Hong, S.-K.; Vo, T.S.; Jeong, J.-R.; Cho, H.K. Photoelectrochemical Water Splitting Properties of Hydrothermally-Grown ZnO Nanorods with Controlled Diameters. Electron. Mater. Lett. 2015, 11, 65–72. [Google Scholar] [CrossRef]
- Sharma, A.; Chakraborty, M.; Thangavel, R.; Udayabhanu, G. Hydrothermal Growth of Undoped and Boron Doped ZnO Nanorods as a Photoelectrode for Solar Water Splitting Applications. J. Sol-Gel Sci. Technol. 2018, 85, 1–11. [Google Scholar] [CrossRef]
- Li, C.; Chen, S.; Wang, Y.; Hou, Z. ZnO/ZnS Heterostructures Grown on Zn Foil Substrate by Hydrothermal Method for Photoelectrochemical Water Splitting. Int. J. Hydrogen Energy 2019, 44, 25416–25427. [Google Scholar] [CrossRef]
- Kobayashi, R.; Kishi, T.; Katayanagi, Y.; Yano, T.; Matsushita, N. Fabrication of Nitrogen-Doped ZnO Nanorod Arrays by Hydrothermal Synthesis and Ambient Annealing. RSC Adv. 2018, 8, 23599–23605. [Google Scholar] [CrossRef] [PubMed]
- Gill, R.; Ghosh, S.; Sharma, A.; Kumar, D.; Nguyen, V.H.; Vo, D.V.N.; Pham, T.D.; Kumar, P. Vertically Aligned ZnO Nanorods for Photoelectrochemical Water Splitting Application. Mater. Lett. 2020, 277, 128295. [Google Scholar] [CrossRef]
- Patel, P.P.; Hanumantha, P.J.; Velikokhatnyi, O.I.; Datta, M.K.; Hong, D.; Gattu, B.; Poston, J.A.; Manivannan, A.; Kumta, P.N. Nitrogen and Cobalt Co-Doped Zinc Oxide Nanowires—Viable Photoanodes for Hydrogen Generation via Photoelectrochemical Water Splitting. J. Power Sources 2015, 299, 11–24. [Google Scholar] [CrossRef]
- Hanh, N.T.; Le Minh Tri, N.; Van Thuan, D.; Thanh Tung, M.H.; Pham, T.D.; Minh, T.D.; Trang, H.T.; Binh, M.T.; Nguyen, M.V. Monocrotophos Pesticide Effectively Removed by Novel Visible Light Driven Cu Doped ZnO Photocatalyst. J. Photochem. Photobiol. Chem. 2019, 382, 111923. [Google Scholar] [CrossRef]
- Mohammed, R.; Ali, M.E.M.; Gomaa, E.; Mohsen, M. Copper Sulfide and Zinc Oxide Hybrid Nanocomposite for Wastewater Decontamination of Pharmaceuticals and Pesticides. Sci. Rep. 2022, 12, 18153. [Google Scholar] [CrossRef]
- Sharma, A.; Bhardwaj, U.; Kushwaha, H.S. ZnO Hollow Pitchfork: Coupled Photo-Piezocatalytic Mechanism for Antibiotic and Pesticide Elimination. Catal. Sci. Technol. 2022, 12, 812–822. [Google Scholar] [CrossRef]
- Zhu, Z.; Guo, F.; Xu, Z.; Di, X.; Zhang, Q. Photocatalytic Degradation of an Organophosphorus Pesticide Using a ZnO/rGO Composite. RSC Adv. 2020, 10, 11929–11938. [Google Scholar] [CrossRef]
- Maleki, A.; Moradi, F.; Shahmoradi, B.; Rezaee, R.; Lee, S.M. The Photocatalytic Removal of Diazinon from Aqueous Solutions Using Tungsten Oxide Doped Zinc Oxide Nanoparticles Immobilized on Glass Substrate. J. Mol. Liq. 2020, 297, 111918. [Google Scholar] [CrossRef]
- Li, M.; Yin, X.; Xu, H.; Li, X.; Cheng, L.; Zhang, L. Interface Evolution of a C/ZnO Absorption Agent Annealed at Elevated Temperature for Tunable Electromagnetic Properties. J. Am. Ceram. Soc. 2019, 102, 5305–5315. [Google Scholar] [CrossRef]
- Wang, Y.; Hao, G.; Zhang, S.; Hui, Z.; Yan, H.; Ke, X. Design and Synthesis of ZnO Nanoparticles Decorated Ultra-Light Nanoscale Reduced Graphene Oxide for Broadband Electromagnetic Wave Absorption. J. Mater. Sci. Mater. Electron. 2021, 32, 20710–20724. [Google Scholar] [CrossRef]
- Anuar, M.F.; Fen, Y.W.; Zaid, M.H.M.; Omar, N.A.S.; Khaidir, R.E.M. Sintering Temperature Effect on Structural and Optical Properties of Heat Treated Coconut Husk Ash Derived SiO2 Mixed with ZnO Nanoparticles. Materials 2020, 13, 2555. [Google Scholar] [CrossRef] [PubMed]
- Wang, J.; Cui, W.; Zhu, L.; Wang, J.; Wei, Q.; Chen, Z.; Shan, M.; Yuan, X.; Hua, J. Structural, Optical, and Magnetic Properties of Low Temperature Hydrothermal Synthesized (Gd, Al)-Codoped ZnO Nanoparticles. J. Sol-Gel Sci. Technol. 2020, 93, 193–201. [Google Scholar] [CrossRef]
- Das, S.; Das, S.; Roychowdhury, A.; Das, D.; Sutradhar, S. Effect of Gd Doping Concentration and Sintering Temperature on Structural, Optical, Dielectric and Magnetic Properties of Hydrothermally Synthesized ZnO Nanostructure. J. Alloys Compd. 2017, 708, 231–246. [Google Scholar] [CrossRef]
- Onwudiwe, D.C.; Arfin, T.; Strydom, C.A. Surfactant Mediated Synthesis of ZnO Nanospheres at Elevated Temperature, and Their Dielectric Properties. Superlattices Microstruct. 2015, 81, 215–225. [Google Scholar] [CrossRef]
- Han, M.; Yin, X.; Ren, S.; Duan, W.; Zhang, L.; Cheng, L. Core/Shell Structured C/ZnO Nanoparticles Composites for Effective Electromagnetic Wave Absorption. RSC Adv. 2016, 6, 6467–6474. [Google Scholar] [CrossRef]
- Ko, Y.H.; Nagaraju, G.; Yu, J.S. Fabrication and Optimization of Vertically Aligned ZnO Nanorod Array-Based UV Photodetectors via Selective Hydrothermal Synthesis. Nanoscale Res. Lett. 2015, 10, 1032. [Google Scholar] [CrossRef]
- Kalpana, V.N.; Kataru, B.A.S.; Sravani, N.; Vigneshwari, T.; Panneerselvam, A.; Devi Rajeswari, V. Biosynthesis of Zinc Oxide Nanoparticles Using Culture Filtrates of Aspergillus Niger: Antimicrobial Textiles and Dye Degradation Studies. OpenNano 2018, 3, 48–55. [Google Scholar] [CrossRef]
- Rambabu, K.; Bharath, G.; Banat, F.; Show, P.L. Green Synthesis of Zinc Oxide Nanoparticles Using Phoenix Dactylifera Waste as Bioreductant for Effective Dye Degradation and Antibacterial Performance in Wastewater Treatment. J. Hazard. Mater. 2021, 402, 123560. [Google Scholar] [CrossRef]
- Dimapilis, E.A.S.; Hsu, C.S.; Mendoza, R.M.O.; Lu, M.C. Zinc Oxide Nanoparticles for Water Disinfection. Sustain. Environ. Res. 2018, 28, 47–56. [Google Scholar] [CrossRef]
- Mishra, P.K.; Mishra, H.; Ekielski, A.; Talegaonkar, S.; Vaidya, B. Zinc Oxide Nanoparticles: A Promising Nanomaterial for Biomedical Applications. Drug Discov. Today 2017, 22, 1825–1834. [Google Scholar] [CrossRef]
- Bykkam, S.; Narsingam, S.; Ahmadipour, M.; Dayakar, T.; Venkateswara Rao, K.; Shilpa Chakra, C.; Kalakotla, S. Few Layered Graphene Sheet Decorated by ZnO Nanoparticles for Anti-Bacterial Application. Superlattices Microstruct. 2015, 83, 776–784. [Google Scholar] [CrossRef]
- Chen, Y.; Ding, H.; Sun, S. Preparation and Characterization of ZnO Nanoparticles Supported on Amorphous SiO2. Nanomaterials 2017, 7, 217. [Google Scholar] [CrossRef] [PubMed]
- Murali, M.; Mahendra, C.; Nagabhushan; Rajashekar, N.; Sudarshana, M.S.; Raveesha, K.A.; Amruthesh, K.N. Antibacterial and Antioxidant Properties of Biosynthesized Zinc Oxide Nanoparticles from Ceropegia Candelabrum L.—An Endemic Species. Spectrochim. Acta–Part Mol. Biomol. Spectrosc. 2017, 179, 104–109. [Google Scholar] [CrossRef]
- Zare, M.; Namratha, K.; Thakur, M.S.; Byrappa, K. Biocompatibility Assessment and Photocatalytic Activity of Bio-Hydrothermal Synthesis of ZnO Nanoparticles by Thymus Vulgaris Leaf Extract. Mater. Res. Bull. 2019, 109, 49–59. [Google Scholar] [CrossRef]
- Ebadi, M.; Zarghami, Z.; Motevalli, K. 40% Efficiency Enhancement in Solar Cells Using ZnO Nanorods as Shell Prepared via Novel Hydrothermal Synthesis. Phys. E Low-Dimens. Syst. Nanostructures 2017, 87, 199–204. [Google Scholar] [CrossRef]
- Sufyan, M.; Mehmood, U.; Qayyum Gill, Y.; Nazar, R.; Ul Haq Khan, A. Hydrothermally Synthesize Zinc Oxide (ZnO) Nanorods as an Effective Photoanode Material for Third-Generation Dye-Sensitized Solar Cells (DSSCs). Mater. Lett. 2021, 297, 130017. [Google Scholar] [CrossRef]
- Kumar, V.; Gupta, R.; Bansal, A. Hydrothermal Growth of ZnO Nanorods for Use in Dye-Sensitized Solar Cells. ACS Appl. Nano Mater. 2021, 4, 6212–6222. [Google Scholar] [CrossRef]
- Lei, R.; Zhang, H.; Ni, H.; Chen, R.; Gu, H.; Zhang, B. Novel ZnO Nanoparticles Modified WO3 Nanosheet Arrays for Enhanced Photocatalytic Properties under Solar Light Illumination. Appl. Surf. Sci. 2019, 463, 363–373. [Google Scholar] [CrossRef]
- Yusoff, N.; Kumar, S.V.; Pandikumar, A.; Huang, N.M.; Marlinda, A.R.; An’Amt, M.N. Core-Shell Fe3O4-ZnO Nanoparticles Decorated on Reduced Graphene Oxide for Enhanced Photoelectrochemical Water Splitting. Ceram. Int. 2015, 41, 5117–5128. [Google Scholar] [CrossRef]
- Zamiri, G.; Bagheri, S. Fabrication of Green Dye-Sensitized Solar Cell Based on ZnO Nanoparticles as a Photoanode and Graphene Quantum Dots as a Photo-Sensitizer. J. Colloid Interface Sci. 2018, 511, 318–324. [Google Scholar] [CrossRef] [PubMed]
- Sutar, S.S.; Patil, S.M.; Kadam, S.J.; Kamat, R.K.; Kim, D.; Dongale, T.D. Analysis and Prediction of Hydrothermally Synthesized ZnO-Based Dye-Sensitized Solar Cell Properties Using Statistical and Machine-Learning Techniques. ACS Omega 2021, 6, 29982–29992. [Google Scholar] [CrossRef]
- Muchuweni, E.; Sathiaraj, T.S.; Nyakotyo, H. Hydrothermal Synthesis of ZnO Nanowires on Rf Sputtered Ga and Al Co-Doped ZnO Thin Films for Solar Cell Application. J. Alloys Compd. 2017, 721, 45–54. [Google Scholar] [CrossRef]
- Saleh, S.M.; Soliman, A.M.; Sharaf, M.A.; Kale, V.; Gadgil, B. Influence of Solvent in the Synthesis of Nano-Structured ZnO by Hydrothermal Method and Their Application in Solar-Still. J. Environ. Chem. Eng. 2017, 5, 1219–1226. [Google Scholar] [CrossRef]
- Yuvaraj, S.; Fernandez, A.C.; Sundararajan, M.; Dash, C.S.; Sakthivel, P. Hydrothermal Synthesis of ZnO–CdS Nanocomposites: Structural, Optical and Electrical Behavior. Ceram. Int. 2020, 46, 391–402. [Google Scholar] [CrossRef]
- Alam, M.S.; Nahar, B.; Gafur, M.A.; Seong, G.; Hossain, M.Z. Forced Convective Heat Transfer Coefficient Measurement of Low Concentration Nanorods ZnO–Ethylene Glycol Nanofluids in Laminar Flow. Nanomaterials 2022, 12, 1568. [Google Scholar] [CrossRef]
- Wang, X.; He, Y.; Chen, M.; Hu, Y. ZnO-Au Composite Hierarchical Particles Dispersed Oil-Based Nanofluids for Direct Absorption Solar Collectors. Sol. Energy Mater. Sol. Cells 2018, 179, 185–193. [Google Scholar] [CrossRef]
- Quadri, T.W.; Olasunkanmi, L.O.; Fayemi, O.E.; Solomon, M.M.; Ebenso, E.E. Zinc Oxide Nanocomposites of Selected Polymers: Synthesis, Characterization, and Corrosion Inhibition Studies on Mild Steel in HCl Solution. ACS Omega 2017, 2, 8421–8437. [Google Scholar] [CrossRef]
- Lee, K.S.; Park, C.W.; Kim, J.D. Synthesis of ZnO/Activated Carbon with High Surface Area for Supercapacitor Electrodes. Colloids Surf. Physicochem. Eng. Asp. 2018, 555, 482–490. [Google Scholar] [CrossRef]
- Gupta, M.K.; Kumar, Y.; Sonnathi, N.; Sharma, S.K. Hydrothermally Grown Zinc Oxide Nanostructures@Carbon Composites for Supercapacitor Application. Phys. Status Solidi A 2023, 220, 2200451. [Google Scholar] [CrossRef]
- Nagaraju, Y.S.; Ganesh, H.; Veeresh, S.; Vijeth, H.; Basappa, M.; Devendrappa, H. Self-Templated One-Step Hydrothermal Synthesis of Hierarchical Actinomorphic Flower-like SnO2-ZnO Nanorods for High-Performance Supercapacitor Application. J. Electroanal. Chem. 2021, 900, 115741. [Google Scholar] [CrossRef]
- Paraschiv, C.; Hristea, G.; Iordoc, M.; Sbarcea, B.-G.; Marinescu, V. Hydrothermal Growth of ZnO/GO Hybrid as an Efficient Electrode Material for Supercapacitor Applications. Scr. Mater. 2021, 195, 113708. [Google Scholar] [CrossRef]
- Isawi, H.; El-Sayed, M.H.; Feng, X.; Shawky, H.; Abdel Mottaleb, M.S. Surface Nanostructuring of Thin Film Composite Membranes via Grafting Polymerization and Incorporation of ZnO Nanoparticles. Appl. Surf. Sci. 2016, 385, 268–281. [Google Scholar] [CrossRef]
- Sheik Mydeen, S.; Raj Kumar, R.; Kottaisamy, M.; Vasantha, V.S. Biosynthesis of ZnO Nanoparticles through Extract from Prosopis Juliflora Plant Leaf: Antibacterial Activities and a New Approach by Rust-Induced Photocatalysis. J. Saudi Chem. Soc. 2020, 24, 393–406. [Google Scholar] [CrossRef]
- Zare, M.; Namratha, K.; Alghamdi, S.; Mohammad, Y.H.E.; Hezam, A.; Zare, M.; Drmosh, Q.A.; Byrappa, K.; Chandrashekar, B.N.; Ramakrishna, S.; et al. Novel Green Biomimetic Approach for Synthesis of ZnO-Ag Nanocomposite; Antimicrobial Activity against Food-Borne Pathogen, Biocompatibility and Solar Photocatalysis. Sci. Rep. 2019, 9, 8303. [Google Scholar] [CrossRef]
- Prabakaran, E.; Pillay, K. RSC Advances Synthesis of N-Doped ZnO Nanoparticles with Cabbage Morphology as a Catalyst for the efficient Photocatalytic Degradation of Methylene Blue under UV and Visible Light. RSC Adv. 2019, 9, 7509–7535. [Google Scholar] [CrossRef]
- Akkari, M.; Aranda, P.; Ben Rhaiem, H.; Ben Haj Amara, A.; Ruiz-Hitzky, E. ZnO/Clay Nanoarchitectures: Synthesis, Characterization and Evaluation as Photocatalysts. Appl. Clay Sci. 2016, 131, 131–139. [Google Scholar] [CrossRef]
- Danwittayakul, S.; Jaisai, M.; Dutta, J. Efficient Solar Photocatalytic Degradation of Textile Wastewater Using ZnO/ZTO Composites. Appl. Catal. B Environ. 2015, 163, 1–8. [Google Scholar] [CrossRef]
- Wang, Y.; Yang, Y.; Xi, L.; Zhang, X.; Jia, M.; Xu, H.; Wu, H. A Simple Hydrothermal Synthesis of Flower-like ZnO Microspheres and Their Improved Photocatalytic Activity. Mater. Lett. 2016, 180, 55–58. [Google Scholar] [CrossRef]
- Zhang, S.; Tang, F.; Liu, J.; Che, W.; Su, H.; Liu, W.; Huang, Y.; Jiang, Y.; Yao, T.; Liu, Q.; et al. MoS2-Coated ZnO Nanocomposite as an Active Heterostructure Photocatalyst for Hydrogen Evolution. Radiat. Phys. Chem. 2017, 137, 104–107. [Google Scholar] [CrossRef]

| Precursor | Reaction Temp. (°C) | Reaction Time (h) | Morphology of Product | Reference |
|---|---|---|---|---|
| ZnCl2 (Merck) (pH = 5, 7, 12) | 160 | 3 | Rod-like ZnO and Cube-like ZnO | [80] |
| Zn(NO3)2·6H2O (98%) & C6H12N4 (99%) (Chongqing Chuandong Chemical Reagent Corp., Chongqing, China) | 120 | 10 | ZnO NPs, NRs, Mixture (NPs + NRs), NFs (Aggregation of NPs and NFs) | [81] |
| Zn(NO3)2 & C6H12N4 (1:1) (Sigma Aldrich, St. Louis, MO, USA) | 60, 90, 120 | 3 | ZnO NRs and microrice structured ZnO thin films | [82] |
| Zn(NO3)2 & C6H12N4 (1:1) | 90 | 3 | ZnO NRs | [83] |
| Zn(CH3COO)2·2H2O (Sharlau, Barcelona, Spain) | 170 | 12 | ZnO NRs | [84] |
| Zn(NO3)2·6H2O (Sigma Aldrich) (pH = 12) | 100, 125, 150 | 2 | ZnO NPs, NFs, NRs | [86] |
| 120 | 1,2,3 | |||
| Zn(CH3COO)2·2H2O (Sigma Aldrich) | 170 | 5 | ZnO NFs | [87] |
| Zn(CH3COO)2·2H2O (99.0%, AR) | 160 | 24 | Undoped ZnO and Zn0.95Fe0.05−xNixO (x = 0, 0.02 and 0.05)NRs | [88] |
| Zn(CH3COO)2·2H2O (Sharlau, Barcelona, Spain) & Ag(NO3)2 (Sigma Aldrich, Hamburg, Germany) | 170 | 6 | ZnO NRs and Ag-ZnO Nanocomposites | [89] |
| Equimolar | 95 | 12 | Zn1−xBx O nanostructures | [90] |
| Graphite Powder (Sigma Aldrich) & Zn(NO3)2·6H2O | 80, 90 | 10 | Graphene/ZnO Nanocomposites | [91] |
| Zn(CH3COO)2·2H2O (99.0%) & CuCl2.2H2O (99.0%) | 180 | 10 | CuO, ZnO, CuO/ZnO Nanocomposites | [92] |
| (FeCl3∙6H2O, 97%), (ZnSO4∙7H2O, 99.9%) & (HAuCl4∙3H2O, 98%) (Sigma Aldrich) | 15 min | Ternary α-Fe2O3-ZnO-Au Nanocomposites | [93] | |
| Zn(CH3COO)2·2H2O (Sinopharm Chemical Regent Co., Ltd., Shanghai, China) | 150 135 | 10 8 | PPy/ZnO nanohybrids | [94] |
| ZnCl2 & (Ni(NO3)2.6H2O (Sigma Aldrich, Hamburg, Germany) | 160 | 24 | ZnO/Ni(OH)2 nanocomposites | [96] |
| (Zn(NO3)2·6H2O & HAuCl4. H2O (Sigma Aldrich, Hamburg, Germany) | 87.5 | 8 | Au@ZnO core@shell NPs | [98] |
| FeSO4·7H2O, Fe(NO3)3·9H2O & ZnCl2 (EMERCK, A.R. grade) | 200 | 18 | Fe3O4@ZnO core-shell NPs | [99] |
| Catalyst | Role | Object of Performance Evaluation | Reference |
|---|---|---|---|
| Few-layered graphene/ZnO | Antibacterial | E. coli, S. typhi | [164] |
| ZnO NP–loaded PMAA-g-PA membranes | Antibacterial | E. coli | [185] |
| ZnO–SiO2 | Antibacterial | E. coli | [165] |
| Bio-based ZnO | Antibacterial | E. coli, R. rhodochrous, B. subtilis, V. cholera | [186] |
| ZnO-Ag NPs | Antioxidant | DPPH assay | [187] |
| Rod-like ZnO | Photocatalyst | Methylene blue | [137] |
| N-doped ZnO | Photocatalyst | Methylene blue | [188] |
| ZnO-MoS2-rGO | Photocatalyst | Methylene blue | [133] |
| ZnO/clay | Photocatalyst | Methylene blue | [189] |
| ZnO/Zn-Sn oxide | Photocatalyst | Methylene blue | [190] |
| Flower-like ZnO | Photocatalyst | Methylene blue | [191] |
| ZnO/Sn3O4 | Sensor | Gas sensor | [108] |
| MoS2-coated ZnO | Electrocatalyst | H2 evaluation | [192] |
| Al-doped ZnO | Sensor | Acetaldehyde | [109] |
| ZnO/activated carbon | Electrocatalyst | Supercapacitor | [181] |
| 1D α-MoO3/0D ZnO | Sensor | Ethanol | [110] |
| Polypyrrole/ZnO | Sensor | Ammonia | [94] |
| Fe/Ni-co-doped ZnO | Sensor | Hexahydropyridine | [64] |
Disclaimer/Publisher’s Note: The statements, opinions and data contained in all publications are solely those of the individual author(s) and contributor(s) and not of MDPI and/or the editor(s). MDPI and/or the editor(s) disclaim responsibility for any injury to people or property resulting from any ideas, methods, instructions or products referred to in the content. |
© 2025 by the authors. Licensee MDPI, Basel, Switzerland. This article is an open access article distributed under the terms and conditions of the Creative Commons Attribution (CC BY) license (https://creativecommons.org/licenses/by/4.0/).
Share and Cite
Hossain, M.Z.; Nayem, S.M.A.; Alam, M.S.; Islam, M.I.; Seong, G.; Chowdhury, A.-N. Hydrothermal ZnO Nanomaterials: Tailored Properties and Infinite Possibilities. Nanomaterials 2025, 15, 609. https://doi.org/10.3390/nano15080609
Hossain MZ, Nayem SMA, Alam MS, Islam MI, Seong G, Chowdhury A-N. Hydrothermal ZnO Nanomaterials: Tailored Properties and Infinite Possibilities. Nanomaterials. 2025; 15(8):609. https://doi.org/10.3390/nano15080609
Chicago/Turabian StyleHossain, Muhammad Zamir, S. M. Abu Nayem, Md. Shah Alam, Md. Imran Islam, Gimyeong Seong, and Al-Nakib Chowdhury. 2025. "Hydrothermal ZnO Nanomaterials: Tailored Properties and Infinite Possibilities" Nanomaterials 15, no. 8: 609. https://doi.org/10.3390/nano15080609
APA StyleHossain, M. Z., Nayem, S. M. A., Alam, M. S., Islam, M. I., Seong, G., & Chowdhury, A.-N. (2025). Hydrothermal ZnO Nanomaterials: Tailored Properties and Infinite Possibilities. Nanomaterials, 15(8), 609. https://doi.org/10.3390/nano15080609

